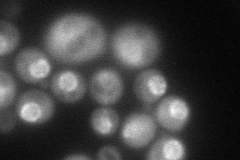
YKR082W
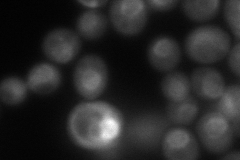
YKR082W
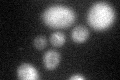
YKR082W

View description
Subunit of the Nup84p subcomplex of the nuclear pore complex (NPC), localizes to both sides of the NPC, required to establish a normal nucleocytoplasmic concentration gradient of the GTPase Gsp1p
Localization:
Intensity:
Fold change:
Significance:
-
C’ GFP library in SD

below threshold11.87 -
N' NOP1pr-GFP in SD
nuclear periphery116.062 -
N' TEF2pr-mCherry in SD
punctate,nuclear periphery102.093 -
N' NATIVEpr-GFP in SD

punctate,nuclear periphery32.0691 -
N' TEF2pr-VC and Cyto-VN in SD

#N/A0 -
C’ GFP library in SD+DTT
cytosol16.381.37No -
C’ GFP library in SD+H2O2

cytosol16.121.35No -
C’ GFP library in Starvation Media

cytosolN/AN/AYes -
C’ GFP library on the background of Pup2-DaMP

N/A -
C’ GFP library on the background of CCT mutant

N/A0N/AYes
